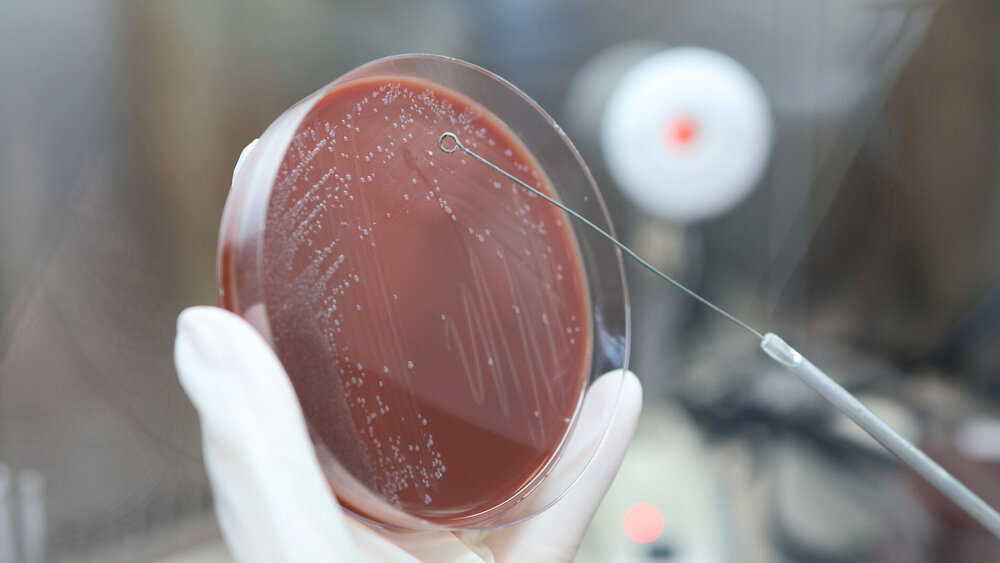

Amphibienhautschleim als Antibiotikaersatz?
Axolotl sind bekannt für ihre Fähigkeit, Gliedmaßen, Organe und sogar Teile des Gehirns und Herzens nachwachsen zu lassen. Doch die Gattung Ambystoma mexicanum kann noch mehr. Ihre Schleimhaut schützt die Tiere vor Krankheitserregern, genauer gesagt: die darin enthaltenen antimikrobiellen Peptide (AMP). Diese Eigenschaft macht das Amphibium für die Medizin interessant, denn viele Forschende suchen aktuell nach neuen Zielmolekülen, mit denen immer weniger wirksame Antibiotika ersetzt werden können. AMP gehören dabei zu den vielversprechenden Kandidaten. Sie sind Teil des angeborenen Immunsystems und kommen in fast allen lebenden Organismen vor.
Ein Forschungsteam für Regenerationsbiologie an der Klinik für Plastische, Ästhetische, Hand- und Wiederherstellungschirurgie der Medizinischen Hochschule Hannover (MHH), hat sich mit verschiedenen AMP aus dem Hautschleim der im Labor lebenden Axolotl beschäftigt. Dabei konnten die Forschenden zeigen, dass die AMPs nicht nur gegen multiresistente Bakterien wie den Krankenhauskeim Methicillin-resistenten Staphylococcus aureus (MRSA) wirksam waren. Sie konnten auch Krebszellen erfolgreich bekämpfen. Die Ergebnisse sind in der Fachzeitschrift „Plos one“ veröffentlicht worden.
Schleim durch sanfte Massage gewonnen
„Antimikrobielle Peptide könnten zukünftig eine Alternative zu Antibiotika sein. Sie weisen ein breites Wirkungsspektrum auf und gleichzeitig ist es für die Erreger schwieriger, Resistenzen zu entwickeln“, sagt Klinikdirektor Prof. Dr. Peter M. Vogt. Um den Hautschleim zu gewinnen, wurden die Axolotl mit sterilen Handschuhen sanft massiert und der produzierte Schleim mit sterilen Schabern von den Handschuhen abgenommen – alles gemäß den Richtlinien des deutschen Tierschutzgesetzes. Unter den im Schleim gewonnenen tausenden AMP wurden in Zusammenarbeit mit dem Fraunhofer Institut für Toxikologie und Experimentelle Medizin ITEM in Hannover 22 wahrscheinlich wirksame Peptidkandidaten herausgesucht und synthetisch hergestellt.
„Das ist aufwändig und teuer, aber AMP lassen sich leider nicht so einfach in Mikroorganismen herstellen wie einige Antibiotika“, erklärt die Biologin Dr. Sarah Strauß. Der Grund dafür liegt im chemischen Aufbau und Wirkmechanismus der AMP: Sie enthalten Aminosäuren mit positiver Ladung und haben wasserabweisende Anteile. Damit können sie an die Zellwand von Bakterien binden. Dort verursachen sie kleine Löcher oder dringen in die Zelle ein und binden an Moleküle. Beides schädigt die Zelle und führt zum Tod. Auch gegen Pilze und verschiedene Viren können AMP wirken.
Wirksamkeit gegen MRSA
Der besondere chemische Aufbau, so vermutet Teamleiterin Strauß, könnte zur Wirksamkeit der AMP gegen resistente Bakterienstämme beitragen und möglicherweise das Risiko einer Resistenz mindern. Das bietet der Medizin einen entscheidenden Vorteil, denn das Problem der Resistenzentwicklung betrifft zunehmend auch sogenannte Reserveantibiotika. „Vier unserer Axolotl-AMPs zeigten eine Wirksamkeit gegen MRSA, die mitunter sogar besser war als die des Reserveantibiotikums Vancomycin“, stellt die Biologin fest. „Die Ergebnisse gegen MRSA sind besonders bedeutsam, weil die Verbreitung dieses multiresistenten Bakterienstammes mit dem übermäßigen Einsatz von Antibiotika sowohl im Gesundheitswesen als auch in der Landwirtschaft weiter zunehmen wird“, erklärt Vogt.
Eine antikarzinogene Wirkung fanden die Forschenden bei drei der vier AMPs, die auch eine signifikante Hemmung von MRSA aufwiesen. In Zellkultur lösten diese bei Brustkrebszellen einen sogenannten programmierten Zelltod aus: ein gesteuertes biologisches Programm, bei dem die betroffene Zelle stirbt. „Dabei haben wir beobachtet, dass die Peptide ganz gezielt Krebszellen töten, ohne gesunde Brustgewebszellen anzugreifen“, betont Strauß. „Insgesamt deuten unsere Ergebnisse darauf hin, dass diese identifizierten AMP vielversprechende Kandidaten für die Bekämpfung von Antibiotikaresistenzen und für Strategien zur Krebsbekämpfung sein könnten.“ Um das zu überprüfen, sind allerdings weitere Untersuchungen nötig.
Dastagir N, Liebsch C, Kutz J, Wronski S, Pich A, Obed D, Vogt PM, Bucan V, Strauß S. Identification of antimicrobial peptides from the Ambystoma mexicanum displaying antibacterial and antitumor activity. PLoS One. 2025 Mar 5;20(3):e0316257. doi: 10.1371/journal.pone.0316257. PMID: 40043049; PMCID: PMC11882074.